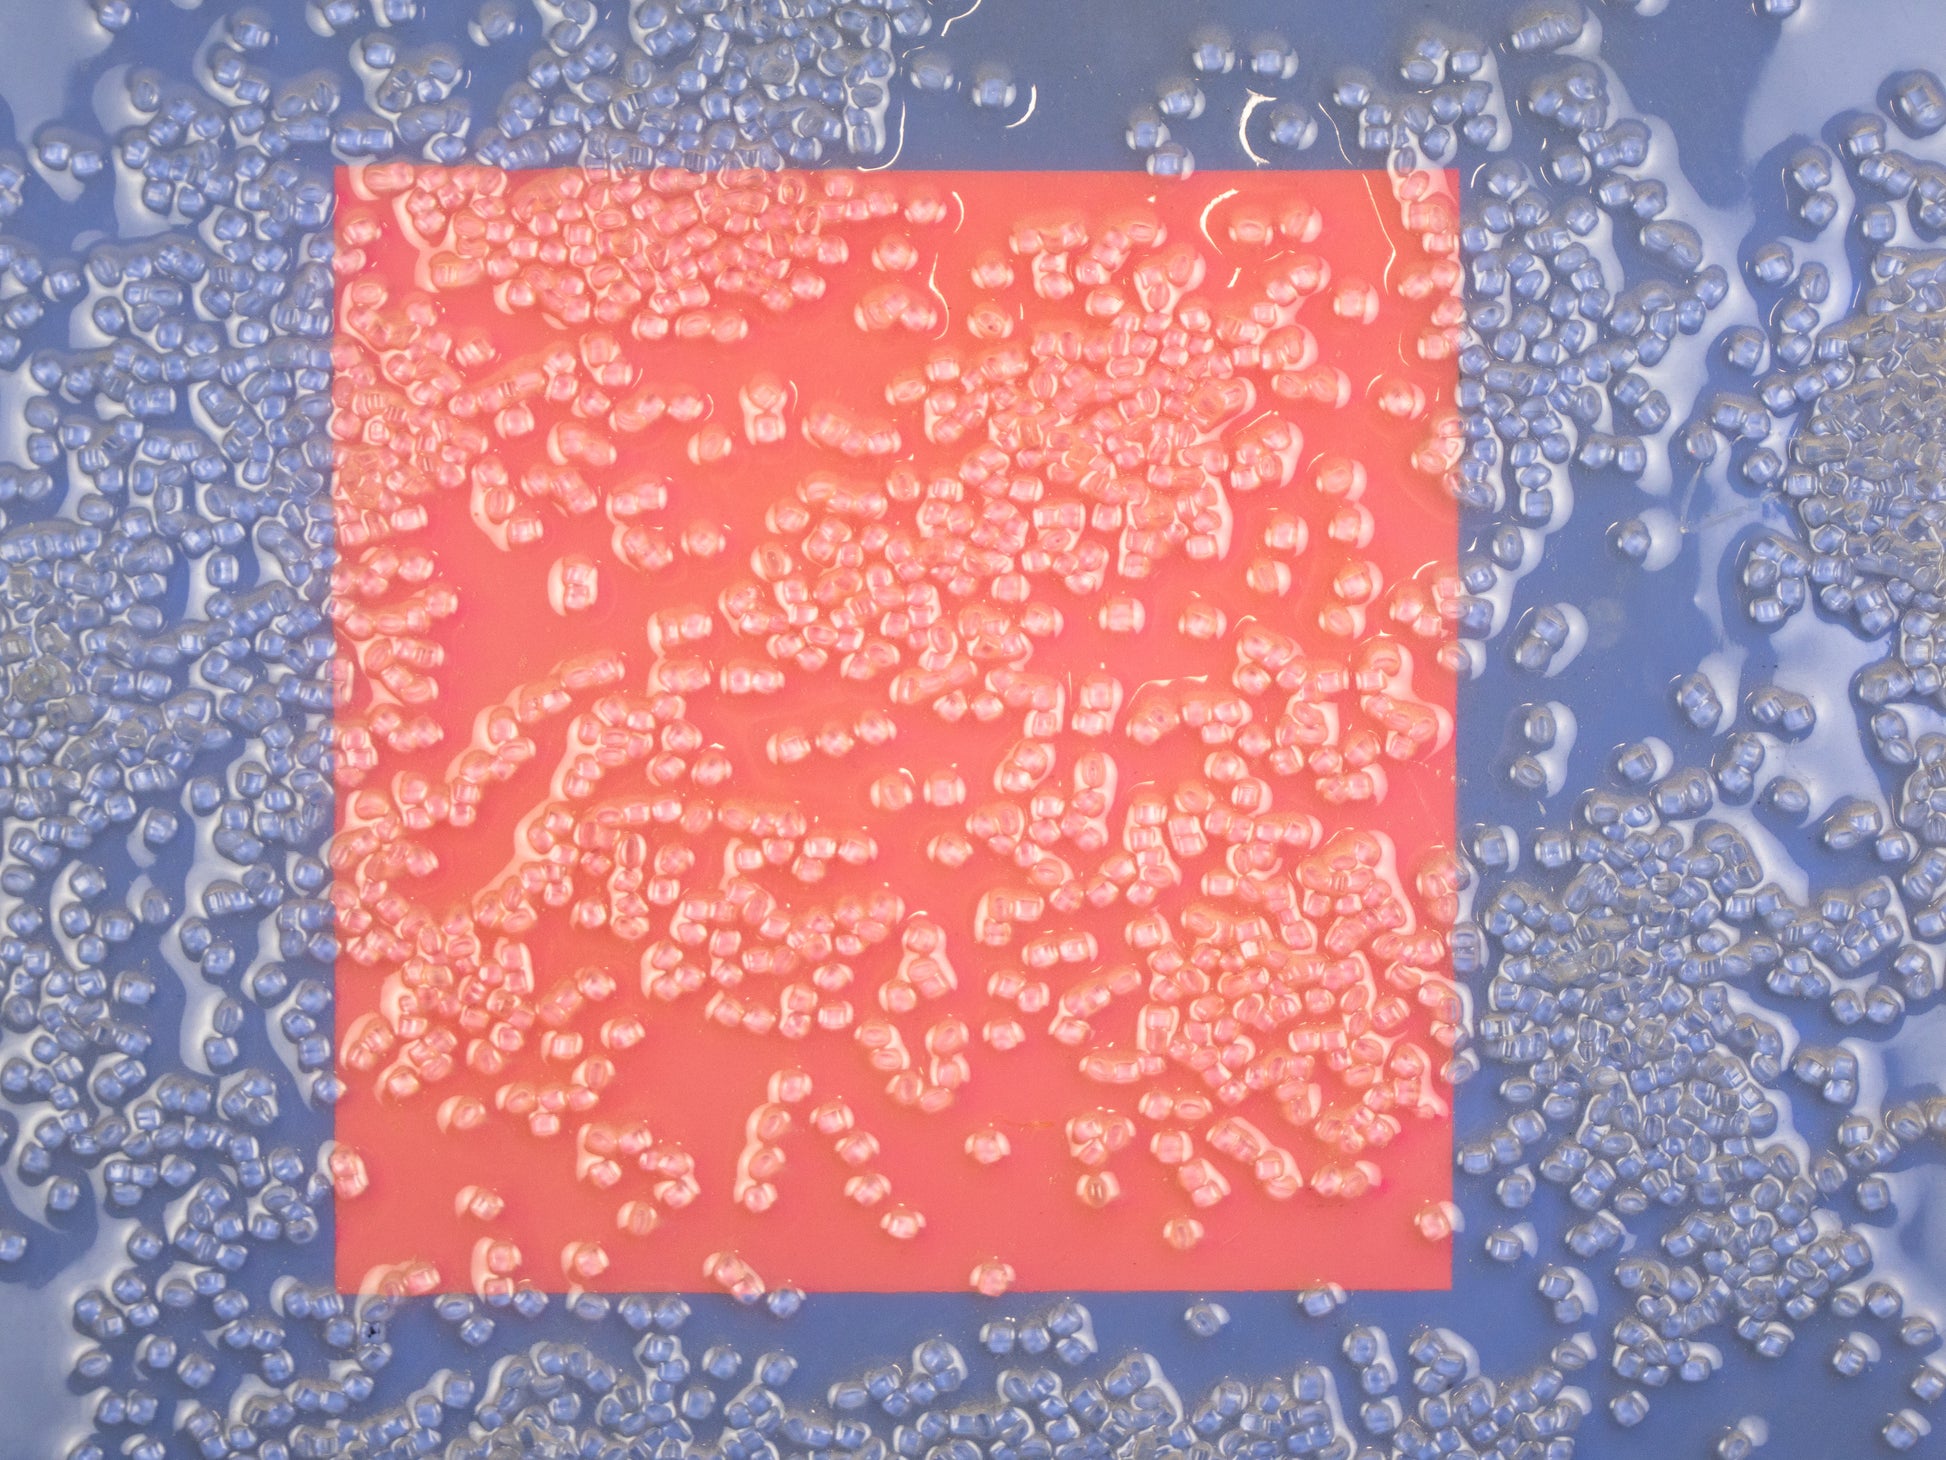

serjirism
Inside Circles
Couldn't load pickup availability
Come close and see the true essence of the work. You will see nothing but circles!
17.5 x 17.5 in

-
Breathing vitality into scrap
In the warehouse, discarded industrial materials find new life as captivating works of art. Amongst the clang of machinery and the scent paint, creativity flourishes, transforming forgotten scraps into pieces that captivate and inspire.
-
Thank you
With evey purchase you are helping the planet to solve the industrial waste problem and giving kids the opporunity to expand their creativity in a sustainable way in Amerca.

We are looking into the future
For a better word, Using technology as our medium to create art

BECOME A SERJIRISM EMBASSADOR BY BUYING ART
We do greatly appreciate all our investors.
Evey time you buy one of our masterpieces, you are helping to reach more people and institutions to make a greater positive change on the planet.

Art Innovation
Futuritic - Industrial - Contemporary - Art